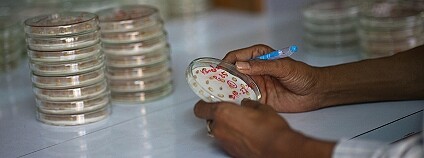

reklama
reklama
ZprávyPlzeňská zoo dokončuje projekt záchrany ohrožené zmije v Íránu9.7.2018 00:12 | PLZEŇ
(ČTK)
 Odborníci z plzeňské zoo zachraňují už čtvrtým rokem silně ohroženou zmije Latifovu, která se vyskytuje pouze v jednom údolí v pohoří Alborz v severním Íránu. Spolupracují s místním institutem i s obyvateli. Pětiletý projekt je financovaný sbírkami zoo, stockholmskou herpetologickou asociací a ochránci zmijí Viper Specialists. Největším úspěchem je, že se podařilo zastavit legální komerční odchyt zmijí na odběr jedu pro farmacii, řekl chovatel zoo Jan Dohnal. Odborníci z plzeňské zoo zachraňují už čtvrtým rokem silně ohroženou zmije Latifovu, která se vyskytuje pouze v jednom údolí v pohoří Alborz v severním Íránu. Spolupracují s místním institutem i s obyvateli. Pětiletý projekt je financovaný sbírkami zoo, stockholmskou herpetologickou asociací a ochránci zmijí Viper Specialists. Největším úspěchem je, že se podařilo zastavit legální komerční odchyt zmijí na odběr jedu pro farmacii, řekl chovatel zoo Jan Dohnal.V České Lípě je tularemie zajíců, nemoc je přenosná na člověka9.7.2018 00:10 | Č. LÍPA
(ČTK)
 V České Lípě je tularemie zajíců, nemoc je přenosná na člověka. Ohnisko je v Dubici, mimořádná opatření k zamezení šíření této nákazy se vztahují na celé město i na Dolní Libchavu. Ve čtvrtek to sdělil mluvčí českolipské radnice Václav Šámal. V České Lípě je tularemie zajíců, nemoc je přenosná na člověka. Ohnisko je v Dubici, mimořádná opatření k zamezení šíření této nákazy se vztahují na celé město i na Dolní Libchavu. Ve čtvrtek to sdělil mluvčí českolipské radnice Václav Šámal.
Ostravská zoo očekává rekordní počet vylíhnutých plameňáků8.7.2018 01:00 | OSTRAVA
(ČTK)
 Ostravská zoologická zahrada by se letos mohla dočkat rekordního počtu mláďat plameňáků kubánských, kteří se tam nyní líhnou. Zatím přišlo na svět pět mláďat a ošetřovatelé počítají s tím, že dalších osm by se ještě mělo vylíhnout. Pokud by chovné páry odchovaly všech 13 mláďat, překonaly by rekord z loňského roku, kdy se podařilo odchovat 12 mláďat, řekla minulý týden mluvčí zahrady Šárka Nováková. Ostravská zoologická zahrada by se letos mohla dočkat rekordního počtu mláďat plameňáků kubánských, kteří se tam nyní líhnou. Zatím přišlo na svět pět mláďat a ošetřovatelé počítají s tím, že dalších osm by se ještě mělo vylíhnout. Pokud by chovné páry odchovaly všech 13 mláďat, překonaly by rekord z loňského roku, kdy se podařilo odchovat 12 mláďat, řekla minulý týden mluvčí zahrady Šárka Nováková.
První řetězce vyřazují z prodeje jednorázové plastové výrobky7.7.2018 00:55
(ČTK)
 Řetězce Lidl a Kaufland v Česku vyřadí z prodeje do konce příštího roku jednorázové plastové výrobky jako brčka, kelímky, talíře a příbory na jedno použití či vatové tyčinky do uší obsahující plast. Místo nich nabídnou výrobky z alternativních a recyklovatelných materiálů. K podobnému kroku se na začátku června přihlásil i nábytkářský řetězec IKEA. Vyjádření dalších řetězců se zjišťuje. Řetězce Lidl a Kaufland v Česku vyřadí z prodeje do konce příštího roku jednorázové plastové výrobky jako brčka, kelímky, talíře a příbory na jedno použití či vatové tyčinky do uší obsahující plast. Místo nich nabídnou výrobky z alternativních a recyklovatelných materiálů. K podobnému kroku se na začátku června přihlásil i nábytkářský řetězec IKEA. Vyjádření dalších řetězců se zjišťuje.Fotopast potvrdila přítomnost vlků v Lužických horách6.7.2018 01:03 | NOVÝ BOR
(ČTK)
Naděje pro vymírající nosorožce: v laboratoři se podařilo vyvinout první hybridní embryo5.7.2018 01:01 | PRAHA
(Ekolist.cz)
 Nosorožci bílí severní jsou na samém pokraji vyhynutí. Na světě přežívají pouze dvě samice tohoto druhu. Za použití metod umělé reprodukce ale nyní vědci zcela poprvé vyvinuli hybridní embryo. Došlo k tomu spojením semene ze samce bílého severního a vajíčka samice příbuzného nosorožce bílého jižního. U nosorožců jde vůbec o první případ, kdy bylo v laboratorních podmínkách dosaženo raného stadia vývoje embrya. Vědecký tým dokázal také vytvořit linii kmenových buněk z embrya nosorožců bílých jižních vykazující typické znaky embryonálních kmenových buněk. Tento vědecký pokrok, klíčový pro záchranu nosorožců bílých severních, byl ve středu 4. července publikován ve vědeckém časopise Nature Communications. Informuje o tom Safari Park Dvůr Králové. Nosorožci bílí severní jsou na samém pokraji vyhynutí. Na světě přežívají pouze dvě samice tohoto druhu. Za použití metod umělé reprodukce ale nyní vědci zcela poprvé vyvinuli hybridní embryo. Došlo k tomu spojením semene ze samce bílého severního a vajíčka samice příbuzného nosorožce bílého jižního. U nosorožců jde vůbec o první případ, kdy bylo v laboratorních podmínkách dosaženo raného stadia vývoje embrya. Vědecký tým dokázal také vytvořit linii kmenových buněk z embrya nosorožců bílých jižních vykazující typické znaky embryonálních kmenových buněk. Tento vědecký pokrok, klíčový pro záchranu nosorožců bílých severních, byl ve středu 4. července publikován ve vědeckém časopise Nature Communications. Informuje o tom Safari Park Dvůr Králové.
Jsou údaje od amatérských ornitologů správně? Někdy jsou dokonce lepší než od odborníků4.7.2018 01:09 | PRAHA
(Ekolist.cz)
 Přibližně před dvěma týdny si virtuální databáze pozorování ptactva eBird připsala záznam s pořadovým číslem 500 000 000. Na to, že tahle platforma pod taktovkou ornitologů z Cornell Lab vznikla teprve v roce 2002, je to dost úctyhodný výkon. Má ale masa shromážděných a digitálně zaznamenaných pozorování amatérských ornitologů nějaké praktické využití? Píše o tom server Wildlife. Přibližně před dvěma týdny si virtuální databáze pozorování ptactva eBird připsala záznam s pořadovým číslem 500 000 000. Na to, že tahle platforma pod taktovkou ornitologů z Cornell Lab vznikla teprve v roce 2002, je to dost úctyhodný výkon. Má ale masa shromážděných a digitálně zaznamenaných pozorování amatérských ornitologů nějaké praktické využití? Píše o tom server Wildlife.
Jen čtvrtina lidí se zapojila do akcí na ochranu přírody4.7.2018 00:40
(ČTK)
 Většina lidí v ČR ví, jak se chovat šetrně k životnímu prostředí, jen čtvrtina se ale v posledních pěti letech aktivně zapojila do nějaké akce na ochranu přírody. Vyplývá to z průzkumu Centra pro výzkum veřejného mínění (CVVM) Sociologického ústavu Akademie věd ČR. Od roku 2004, kdy centrum tyto postoje sleduje, se aktivita obyvatel Česka k životnímu prostředí snížila. Výsledky zveřejnilo CVVM v neděli. Většina lidí v ČR ví, jak se chovat šetrně k životnímu prostředí, jen čtvrtina se ale v posledních pěti letech aktivně zapojila do nějaké akce na ochranu přírody. Vyplývá to z průzkumu Centra pro výzkum veřejného mínění (CVVM) Sociologického ústavu Akademie věd ČR. Od roku 2004, kdy centrum tyto postoje sleduje, se aktivita obyvatel Česka k životnímu prostředí snížila. Výsledky zveřejnilo CVVM v neděli.Stát nedostatečně kontroluje soukromé lesníky, stěžuje si sdružení4.7.2018 00:22
(ČTK)
 Sdružení místních samospráv si stěžuje na nedostatečnou státní kontrolu vlastníků soukromých lesů kvůli kůrovci. Zvláště mu vadí postoj fyzických osob, které o kůrovci ve svém lese ani nemusí vědět. Ministerstvo zemědělství včera v reakci sdělilo, že pokud vlastník nedělá potřebná opatření, měli by okolní lesníci upozornit orgány státní správy lesů nebo inspekci životního prostředí, které by měly následně uplatňovat sankce až po exekuci majetku. Stát podle ministerstva zvažuje i obnovení lesních úřadů na okresní úrovni. Sdružení místních samospráv si stěžuje na nedostatečnou státní kontrolu vlastníků soukromých lesů kvůli kůrovci. Zvláště mu vadí postoj fyzických osob, které o kůrovci ve svém lese ani nemusí vědět. Ministerstvo zemědělství včera v reakci sdělilo, že pokud vlastník nedělá potřebná opatření, měli by okolní lesníci upozornit orgány státní správy lesů nebo inspekci životního prostředí, které by měly následně uplatňovat sankce až po exekuci majetku. Stát podle ministerstva zvažuje i obnovení lesních úřadů na okresní úrovni.Studie: Podíl dieselů na prodeji aut v EU klesne na pět procent4.7.2018 00:20 | BRUSEL
(ČTK)
Policie se zabývá případem pumy, která utekla ze zoo ve Zvoli4.7.2018 00:15 | ZVOLE
(ČTK)
Francie: Dron spadl v areálu jaderné elektrárny, škody prý nejsou4.7.2018 00:12
(ČTK)
 Aktivisté mezinárodní ekologické organizace Greenpeace navedli dálkově řízené letadélko na jadernou elektrárnu v jihovýchodní Francii, v jejímž areálu se nakonec dron zřítil. Greenpeace, která takto chtěla upozornit, že francouzská jaderná zařízení nejsou dostatečně bezpečnostně zajištěná, včera o akci zveřejnila videozáznam. Nejsou hlášeny výrazné škody. Aktivisté mezinárodní ekologické organizace Greenpeace navedli dálkově řízené letadélko na jadernou elektrárnu v jihovýchodní Francii, v jejímž areálu se nakonec dron zřítil. Greenpeace, která takto chtěla upozornit, že francouzská jaderná zařízení nejsou dostatečně bezpečnostně zajištěná, včera o akci zveřejnila videozáznam. Nejsou hlášeny výrazné škody.V plzeňské zoo mají mláďata dvou vzácných druhů jedovatých hadů4.7.2018 00:10 | PLZEŇ
(ČTK)
 V plzeňské zoo se narodila mláďata dvou velmi vzácných druhů silně jedovatých hadů. Jde o první odchovy osmi chřestýšů arubských, což je jeden z nejohroženějších hadů, a dále o dvě zmije Schweitzerovy. Tyto hady nechová žádná zoo v ČR. Zajímavé je, že mláďata chřestýšů i zmijí mají jiné složení jedu než dospělci a většinou jsou výrazně jedovatější, takže je potřeba být opatrný už při manipulaci s malými hady, řekl chovatel Jan Dohnal. V plzeňské zoo se narodila mláďata dvou velmi vzácných druhů silně jedovatých hadů. Jde o první odchovy osmi chřestýšů arubských, což je jeden z nejohroženějších hadů, a dále o dvě zmije Schweitzerovy. Tyto hady nechová žádná zoo v ČR. Zajímavé je, že mláďata chřestýšů i zmijí mají jiné složení jedu než dospělci a většinou jsou výrazně jedovatější, takže je potřeba být opatrný už při manipulaci s malými hady, řekl chovatel Jan Dohnal.BMW uzavřela miliardový kontrakt s čínskou CATL4.7.2018 00:08
(ČTK)
 Německá automobilka BMW uzavřela kontrakt s největším čínským výrobcem baterií pro elektromobily Contemporary Amperex Technology Ltd (CATL) v hodnotě zhruba jedné miliardy eur (26 miliard Kč). Kontrakt mu umožní postavit továrnu na výrobu článků pro elektrická vozidla v Evropě. Oznámil to mluvčí automobilky Glenn Schmidt. Německá automobilka BMW uzavřela kontrakt s největším čínským výrobcem baterií pro elektromobily Contemporary Amperex Technology Ltd (CATL) v hodnotě zhruba jedné miliardy eur (26 miliard Kč). Kontrakt mu umožní postavit továrnu na výrobu článků pro elektrická vozidla v Evropě. Oznámil to mluvčí automobilky Glenn Schmidt.Provozovatel kompostárny z České Lípy dostal pokutu 450.000 Kč4.7.2018 00:08 | Č. LÍPA
(ČTK)
Pokutu 450.000 korun uložila Česká inspekce životního prostředí (ČIŽP) firmě KOMPOSTÁRNA CL, jež provozuje u České Lípy kompostárnu. Důvodem bylo porušení schváleného provozního řádu zařízení, kdy mohlo dojít k ohrožení a kontaminaci vod. V tiskové zprávě o tom informovala zastupující mluvčí inspekce Jana Jandová. Podle ní je to už čtvrtá pokuta pro tuto firmu za posledních sedm let. Jednatel firmy Pavel Hauft v pondělí řekl, že již nápravu provedli.
Až nyní se podařilo doložit, že mříže na opuštěných dolech brání vstupu jen lidem, ale netopýrům nevadí3.7.2018 01:09 | PRAHA
(Ekolist.cz)
 Masivní zábrany, svářené ocelové trubky, mříže a nejrůznější poklopy nemají vliv na to, jestli se do podzemních dolů úspěšně dostanou netopýři. Naštěstí. S plošnou instalací těchto bezpečnostních prvků se totiž začalo v roce 2010, ale teprve letos se potvrdilo, že opravdu brání ve vstupu jen lidem, a ne i netopýrovitým. Dříve to jasné nebylo. O podrobnostech píše Phys.org. Masivní zábrany, svářené ocelové trubky, mříže a nejrůznější poklopy nemají vliv na to, jestli se do podzemních dolů úspěšně dostanou netopýři. Naštěstí. S plošnou instalací těchto bezpečnostních prvků se totiž začalo v roce 2010, ale teprve letos se potvrdilo, že opravdu brání ve vstupu jen lidem, a ne i netopýrovitým. Dříve to jasné nebylo. O podrobnostech píše Phys.org.
Z přestupku při protestu na Mostecku je podezřelých 280 aktivistů3.7.2018 00:35 | LOUKA U LITVÍNOVA
(ČTK)
 Policie v souvislosti se sobotním protestem proti těžbě uhlí na Mostecku zajistila 280 lidí. Podezřívá je z přestupkového jednání. Všechny už policie propustila na svobodu. V neděli to řekla mluvčí krajské policie Jana Slámová. Pětidenní klimatický tábor v Louce u Litvínova v neděli skončil. Severočeské doly budou škody kvůli zastavení prací v lomu Bílina teprve vyčíslovat. Při zásahu policie podle aktivistů chybovala, jednomu účastníkovi údajně zlomil policista dvě žebra. Policie se k tomu zatím vyjadřovat nebude, bezpečnostní opatření teprve bude vyhodnocovat. Policie v souvislosti se sobotním protestem proti těžbě uhlí na Mostecku zajistila 280 lidí. Podezřívá je z přestupkového jednání. Všechny už policie propustila na svobodu. V neděli to řekla mluvčí krajské policie Jana Slámová. Pětidenní klimatický tábor v Louce u Litvínova v neděli skončil. Severočeské doly budou škody kvůli zastavení prací v lomu Bílina teprve vyčíslovat. Při zásahu policie podle aktivistů chybovala, jednomu účastníkovi údajně zlomil policista dvě žebra. Policie se k tomu zatím vyjadřovat nebude, bezpečnostní opatření teprve bude vyhodnocovat.Čína požádala Kongo o vysoce chráněná zvířata pro dvě své zoo3.7.2018 00:30
(ČTK)
 Čína požádala Kongo o dodání zvířat ze seznamu ohrožených druhů, mezi nimi například o horské gorily nebo trpasličí šimpanzy, aby je umístila ve svých zoologických zahradách. Vyplývá to z dopisu konžského ministra pro životní prostředí partnerovi v Číně. Obsah dopisu se dostal na twitter a vyvolal rozhořčení mezi ochránci přírody, napsal britský list The Guardian. Čína požádala Kongo o dodání zvířat ze seznamu ohrožených druhů, mezi nimi například o horské gorily nebo trpasličí šimpanzy, aby je umístila ve svých zoologických zahradách. Vyplývá to z dopisu konžského ministra pro životní prostředí partnerovi v Číně. Obsah dopisu se dostal na twitter a vyvolal rozhořčení mezi ochránci přírody, napsal britský list The Guardian.Ochránci přírody se lidí ptají, kde se v Praze schovat před horkem3.7.2018 00:26
(ČTK)
 Kam se lidé v Praze chodí schovat před letními horky, se ptají ekologové ze spolku Arnika v nové anketě. Podle nich se Praha dostatečně nepřizpůsobuje změně klimatu, zejména v zastavěných částech se budou teploty v budoucnu ještě zvyšovat. To uvádí i analýza Ústavu výzkumu globální změny Akademie věd ČR, kterou vědci provedli jako podklad pro adaptační strategii Prahy na změnu klimatu. Arnika o anketě informovala ve včerejší tiskové zprávě. Kam se lidé v Praze chodí schovat před letními horky, se ptají ekologové ze spolku Arnika v nové anketě. Podle nich se Praha dostatečně nepřizpůsobuje změně klimatu, zejména v zastavěných částech se budou teploty v budoucnu ještě zvyšovat. To uvádí i analýza Ústavu výzkumu globální změny Akademie věd ČR, kterou vědci provedli jako podklad pro adaptační strategii Prahy na změnu klimatu. Arnika o anketě informovala ve včerejší tiskové zprávě.Vyškov zvýší počet kontejnerů na tříděný odpad3.7.2018 00:21 | VYŠKOV
(ČTK)
 Vyškov se v některých místech potýká s nepořádkem kvůli nedostatečnému počtu kontejnerů na plasty a papír. Město proto počet kontejnerů od července zvýší o několik desítek. Zřídí i speciální úklidovou četu, která bude tzv. separační hnízda pravidelně objíždět. Na tiskové konferenci v tomto týdnu to uvedl místostarosta města Karel Jurka (ODS). Vyškov se v některých místech potýká s nepořádkem kvůli nedostatečnému počtu kontejnerů na plasty a papír. Město proto počet kontejnerů od července zvýší o několik desítek. Zřídí i speciální úklidovou četu, která bude tzv. separační hnízda pravidelně objíždět. Na tiskové konferenci v tomto týdnu to uvedl místostarosta města Karel Jurka (ODS).Turisté opět mohou na šumavskou Medvědí stezku3.7.2018 00:14 | VIMPERK
(ČTK)
 Turisté opět mohou na šumavskou Medvědí stezku u Nové Pece na Prachaticku. Trasa byla zavřená kvůli zpracovávání dřeva z polomů po vichřicích, které Šumavu od loňského léta v několika vlnách zasáhly. Turisté však nesmí na stezky v okolí Rosenauerovy kaple a poblíž Schwarzenberského kanálu. V těchto místech pokračuje zpracování polomového dřeva. Řekl mluvčí šumavského národního parku Jan Dvořák. Turisté opět mohou na šumavskou Medvědí stezku u Nové Pece na Prachaticku. Trasa byla zavřená kvůli zpracovávání dřeva z polomů po vichřicích, které Šumavu od loňského léta v několika vlnách zasáhly. Turisté však nesmí na stezky v okolí Rosenauerovy kaple a poblíž Schwarzenberského kanálu. V těchto místech pokračuje zpracování polomového dřeva. Řekl mluvčí šumavského národního parku Jan Dvořák.Tesla splnila plán, vyrábí 5000 vozů Model 3 týdně3.7.2018 00:13
(ČTK)
 Americkému výrobci elektrických vozů Tesla se podařilo splnit plán a zvýšit výrobu sedanu Model 3 na 5000 týdně. Poslední vůz sjel z montážní linky v neděli ráno, několik hodin po půlnoci, kterou zakladatel a generální ředitel podniku Elon Musk stanovil jako konečný termín. Uvedla to agentura Reuters s odvoláním na zdroje z montážního závodu. Americkému výrobci elektrických vozů Tesla se podařilo splnit plán a zvýšit výrobu sedanu Model 3 na 5000 týdně. Poslední vůz sjel z montážní linky v neděli ráno, několik hodin po půlnoci, kterou zakladatel a generální ředitel podniku Elon Musk stanovil jako konečný termín. Uvedla to agentura Reuters s odvoláním na zdroje z montážního závodu.V jihlavské zoo uhynul samec žirafy, měl střevní potíže3.7.2018 00:10 | JIHLAVA
(ČTK)
 V Zoologické zahradě Jihlava uhynul v pátek večer samec žirafy severní núbijské. Měl akutní závažné střevní potíže. Přesnou příčinu zjišťují veterinární lékaři a další odborníci, další dvě žirafy jsou v pořádku, řekl mluvčí zahrady Martin Maláč. Zahrada žirafy chová pět let. V Zoologické zahradě Jihlava uhynul v pátek večer samec žirafy severní núbijské. Měl akutní závažné střevní potíže. Přesnou příčinu zjišťují veterinární lékaři a další odborníci, další dvě žirafy jsou v pořádku, řekl mluvčí zahrady Martin Maláč. Zahrada žirafy chová pět let.
Ministerstvo zemědělství připravilo katalog, lesníci se dozvědí, kde skladovat dřevo3.7.2018 00:08
(ČTK)
 Ministerstvo zemědělství (MZe) připravilo katalog ploch, kde by vlastníci lesů a zpracovatelé mohli skladovat dříví. Kvůli kůrovcové a větrným kalamitám nebude podle odhadů odbyt až pro 2,4 milionu metrů krychlových dříví, které tak bude nutné uskladnit. V katalogu je prostor o ploše téměř 94 hektarů, kam by se dalo dát až 1,4 milionu metrů krychlových dříví. Úřad to včera sdělil. Katalog obsahuje informace o skladovacích možnostech institucí, jako jsou České dráhy nebo Státní pozemkový úřad, ale také krajů. Ministerstvo zemědělství (MZe) připravilo katalog ploch, kde by vlastníci lesů a zpracovatelé mohli skladovat dříví. Kvůli kůrovcové a větrným kalamitám nebude podle odhadů odbyt až pro 2,4 milionu metrů krychlových dříví, které tak bude nutné uskladnit. V katalogu je prostor o ploše téměř 94 hektarů, kam by se dalo dát až 1,4 milionu metrů krychlových dříví. Úřad to včera sdělil. Katalog obsahuje informace o skladovacích možnostech institucí, jako jsou České dráhy nebo Státní pozemkový úřad, ale také krajů.Praha chystá další kompostárnu u malešické spalovny, kompostárna ve Slivenci oslaví zanedlouho první rok fungování2.7.2018 01:12 | PRAHA
(Ekolist.cz)
 U malešické spalovny v Praze 14 chce magistrát vybudovat další kompostárnu, musí však nejprve záměr projednat s městskou částí. Sdělili to 6. června radní hl. m. Prahy Jana Plamínková a šéf magistrátního oddělení odpadů Radim Polák na prohlídce kompostárny v Praze - Slivenci, která je první kompostárnou vybudovanou hlavním městem Praha.
Bude slavit rok fungování, od té doby do ní zhruba tisíc jednotlivců a firem přivezlo 900 tun bioodpadu. U malešické spalovny v Praze 14 chce magistrát vybudovat další kompostárnu, musí však nejprve záměr projednat s městskou částí. Sdělili to 6. června radní hl. m. Prahy Jana Plamínková a šéf magistrátního oddělení odpadů Radim Polák na prohlídce kompostárny v Praze - Slivenci, která je první kompostárnou vybudovanou hlavním městem Praha.
Bude slavit rok fungování, od té doby do ní zhruba tisíc jednotlivců a firem přivezlo 900 tun bioodpadu.
Za úbytek hmyzu mohou nejen klimatické změny nebo agrochemie. Překvapivě také světelný smog2.7.2018 01:09 | PRAHA
(Ekolist.cz)
 Proč máme tak málo hmyzu v povětří? Němečtí výzkumníci si nemyslí, že se jejich drastický úbytek dá vysvětlit jen klimatickými změnami, změnou hospodaření v krajině nebo pesticidy. Nepopírají, že tyto negativní faktory svou podstatnou roli mají, ale přidávají k nim další. Světelné znečištění. Píše o tom ScienceDaily. Proč máme tak málo hmyzu v povětří? Němečtí výzkumníci si nemyslí, že se jejich drastický úbytek dá vysvětlit jen klimatickými změnami, změnou hospodaření v krajině nebo pesticidy. Nepopírají, že tyto negativní faktory svou podstatnou roli mají, ale přidávají k nim další. Světelné znečištění. Píše o tom ScienceDaily.
Kokain v řekách škodí ohroženým úhořům2.7.2018 00:40 | LONDÝN
(ČTK)
 Stopové množství kokainu spláchnutého do řek škodí ohroženým úhořům, zjistila nová studie, o které informoval list The Guardian. Úhoři jsou po požití kokainu hyperaktivní, navíc trpí úbytkem svalů, poškozením žáber a hormonálními změnami. Účinky kokainu na fyziologii úhořů říčních může mařit jejich dlouhou migraci oceány za reprodukcí, uvedli vědci zkoumající dopad drogy. Stopové množství kokainu spláchnutého do řek škodí ohroženým úhořům, zjistila nová studie, o které informoval list The Guardian. Úhoři jsou po požití kokainu hyperaktivní, navíc trpí úbytkem svalů, poškozením žáber a hormonálními změnami. Účinky kokainu na fyziologii úhořů říčních může mařit jejich dlouhou migraci oceány za reprodukcí, uvedli vědci zkoumající dopad drogy.Očekávané mládě slona afrického se ve zlínské zoo narodilo mrtvé2.7.2018 00:38 | ZLÍN
(ČTK)
 Očekávané mládě slona afrického se včera ve zlínské zoologické zahradě narodilo mrtvé, byla to samička s porodní váhou 86 kilogramů. Mělo jít o první slůně africké narozené v Česku. Prvorodička, dvaadvacetiletá slonice Zola, je v pořádku, řekla to mluvčí zoo Romana Bujáčková. Sloni afričtí patří ke kriticky ohroženým druhům. Jejich chov je v Česku i Evropě vzácný, zahrady většinou chovají slony indické, kteří jsou ovladatelnější. V ČR chová slony africké vedle zlínské zahrady jen zoo ve Dvoře Králové nad Labem. Očekávané mládě slona afrického se včera ve zlínské zoologické zahradě narodilo mrtvé, byla to samička s porodní váhou 86 kilogramů. Mělo jít o první slůně africké narozené v Česku. Prvorodička, dvaadvacetiletá slonice Zola, je v pořádku, řekla to mluvčí zoo Romana Bujáčková. Sloni afričtí patří ke kriticky ohroženým druhům. Jejich chov je v Česku i Evropě vzácný, zahrady většinou chovají slony indické, kteří jsou ovladatelnější. V ČR chová slony africké vedle zlínské zahrady jen zoo ve Dvoře Králové nad Labem.
V Austrálii platí zákaz jednorázových igelitek, někteří se zlobí2.7.2018 00:34
(ČTK)
 Vztek a rozčilení vyvolal u některých zákazníků největších australských obchodních řetězců zákaz vydávání jednorázových plastových tašek. Ten platí ve většině australských států od včerejška a obchodníkům za jeho porušení hrozí pokuta, napsala agentura Reuters. Vztek a rozčilení vyvolal u některých zákazníků největších australských obchodních řetězců zákaz vydávání jednorázových plastových tašek. Ten platí ve většině australských států od včerejška a obchodníkům za jeho porušení hrozí pokuta, napsala agentura Reuters.Beroun chce v centru města vybudovat podzemní kontejnery2.7.2018 00:32 | BEROUN
(ČTK)
|
komentáře nejnovější nejčtenější Jan Cidlinský17.5.2026 Antibiotika, hormony i drogy mají zmizet z řek. Evropské čistírny čeká revoluce za miliardy
rady a návodytiskové zprávy11. května 2026 | Vrchlabí do toho!
Vrchlabí do toho!: Vrchlabí do toho! chce vyhrát volby. Nabízí Lukáše Teplého jako nového starostukalendář akcí
19. května 2026 (úterý) Optimalizace odpadových toků: moderní přístup k nakládání s odpady (Online akce, webináře, online )
19. května 2026 (úterý) Optimalizace odpadových toků: moderní přístup k nakládání s odpady (Konference, semináře, školení a stáže, )
19. května 2026 (úterý) 16:30 - 17:30
Indonésie a zejména Bali (Přednášky a diskuse, Praha 8 ) reklama |
Ekolist.cz je vydáván občanským sdružením BEZK. ISSN 1802-9019. Za webhosting a publikační systém TOOLKIT děkujeme Ecn studiu. Navštivte Ecomonitor.
Copyright © BEZK. Copyright © ČTK, TASR. Všechna práva vyhrazena. Publikování nebo šíření obsahu je bez předchozího souhlasu držitele autorských práv zakázáno.
Copyright © BEZK. Copyright © ČTK, TASR. Všechna práva vyhrazena. Publikování nebo šíření obsahu je bez předchozího souhlasu držitele autorských práv zakázáno.